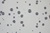

About Automated Image Analysis
In materialography, automated image analysis most often refers to digital quantitative evaluation of a microstructure image.
Quantitative measurements are typically length, width, and area, and are used for the evaluation of materialographic characteristics such as grain size, inclusions, layers, and phases or other constituents.
Digitalization of images enables the handling of high volumes of data, in order to ensure a statistical basis.